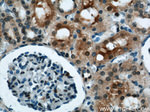
GAPDH Antibody in Immunohistochemistry (Paraffin) (IHC (P))
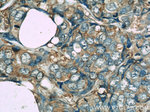
GAPDH Antibody in Immunohistochemistry (Paraffin) (IHC (P))

Search
Proteintech
GAPDH Monoclonal Antibody (1E6D9)
{{$productOrderCtrl.translations['antibody.pdp.commerceCard.promotion.promotions']}}
{{$productOrderCtrl.translations['antibody.pdp.commerceCard.promotion.viewpromo']}}
{{$productOrderCtrl.translations['antibody.pdp.commerceCard.promotion.promocode']}}: {{promo.promoCode}} {{promo.promoTitle}} {{promo.promoDescription}}. {{$productOrderCtrl.translations['antibody.pdp.commerceCard.promotion.learnmore']}}
产品信息
60004-1-IG
种属反应
已发表种属
宿主/亚型
分类
类型
克隆号
抗原
偶联物
形式
浓度
规格
纯化类型
保存液
内含物
保存条件
运输条件
产品详细信息
This antibody is raised against full length GAPDH of human origin. It can recognize the 36 kDa GAPDH protein in most cells/tissues. In addition, a band below 36 kDa can always be detected as the isoform or spliced product of GAPDH. Please note that some physiological factors, such as hypoxia and diabetes, increase GAPDH expression in certain cell types.
Immunogen sequence: MGKVKVGVN GFGRIGRLVT RAAFNSGKVD IVAINDPFID LNYMVYMFQY DSTHGKFHGT VKAENGKLVI NGNPITIFQE RDPSKIKWGD AGAEYVVEST GVFTTMEKAG AHLQGGAKRV IISAPSADAP MFVMGVNHEK YDNSLKIISN ASCTTNCLAP LAKVIHDNFG IVEGLMTTVH AITATQKTVD GPSGKLWRDG RGALQNIIPA STGAAKAVGK VIPELNGKLT GMAFRVPTAN VSVVDLTCRL EKPAKYDDIK KVVKQASEGP LKGILGYTEH QVVSSDFNSD THSSTFDAGA GIALNDHFVK LISWYDNEFG YSNRVVDLMA HMASKE (1-335 aa encoded by B C004109)
靶标信息
GAPDH (Glyceraldehyde-3-phosphate dehydrogenase) is a catalytic enzyme commonly known to be involved in glycolysis. GAPDH exists as a tetramer of identical 37-kDa subunits and catalyzes the reversible reduction of 1,3-bisphosphoglycerate to glyceraldehyde 3-phosphophate in the presence of NADPH. Apart from playing a key role in glycolysis, GAPDH is ubiquitously expressed and displays other activities unrelated to its glycolytic function. GAPDH is reported to be involved in the processes of DNA replication, DNA repair, nuclear RNA export, membrane fusion and microtubule bundling. Studies provide evidence of GAPDH playing an essential part in gene expression observed in apoptosis and as part of the cellular phenotype of age-related neurodegenerative diseases. Further, GAPDH is involved in other cellular processes ranging from membrane fusion, and neuronal apoptosis in cancer. GAPDH is reported to bind to a variety of other proteins, including the amyloid precursor protein, mutations in which cause some forms of Alzheimer's disease (AD), and the polyglutamine tracts of Huntingtin, the protein product aberrant forms of which are causative of Huntington's disease. Associations between GAPDH, actin and tubulin have also be reported. Since GAPDH is expressed at high levels in most tissues, it is useful as protein loading control in Western Blot analysis.
仅用于科研。不用于诊断过程。未经明确授权不得转售。
生物信息学
蛋白别名: 38 kDa BFA-dependent ADP-ribosylation substrate; AAG9; aging-associated gene 9 protein; BARS-38; EC 1.2.1.12; epididymis secretory protein Li 278; epididymis secretory sperm binding protein Li 162eP; GAPA; GAPA-1; GAPC; GAPC-1; GAPC1; GAPCP-1; GAPCp1; GAPD; GAPDH; GAPDH-2; GAPDH-A; glyceraldehyde 3-phosphate dehydrogenase (EC 1.2.1.12); glyceraldehyde 3-phosphate dehydrogenase, testis-specific; Glyceraldehyde-3-phosphate dehydrogenase; glyceraldehyde-3-phosphate dehydrogenase (EC 1.2.1.12); Glyceraldehyde-3-phosphate dehydrogenase 2; glyceraldehyde-3-phosphate dehydrogenase type 2; Glyceraldehyde-3-phosphate dehydrogenase, testis-specific; HGNC:4141; MGC88685; OCAS, p38 component; Oct1 coactivator in S phase, 38 Kd component; Peptidyl-cysteine S-nitrosylase GAPDH; similar to Homo sapiens glyceraldehyde-3-phosphate dehydrogenase (GAPDH) mRNA with GenBank Accession Number M33197.1; Spermatogenic cell-specific glyceraldehyde 3-phosphate dehydrogenase 2; Spermatogenic glyceraldehyde-3-phosphate dehydrogenase; unnamed protein product
基因别名: BARS-38; bb02e05; cb350; cb609; CDABP0047; fb71f08; fk58c09; G3PD; g3pdh; GAPD; Gapd-s; GAPD2; GAPDH; GAPDH-2; GAPDH2; GAPDHS; GAPDS; HEL-S-162eP; HEL-S-278; HSD-35; HSD35; mg:bb02e05; OK/SW-cl.12; wu:fb33a10; wu:fb71f08; wu:fk58c09; wu:ft80f05; zgc:76908
UniProt ID: (Human) P04406, (Human) O14556, (Mouse) P16858, (Rat) P04797, (Rat) Q9ESV6, (Mouse) Q64467, (Zebrafish) Q5XJ10, (Zebrafish) Q5MJ86
Entrez Gene ID: (Human) 2597, (Human) 26330, (Mouse) 14433, (Rat) 24383, (Rat) 66020, (Mouse) 14447, (Zebrafish) 317743, (Zebrafish) 406367